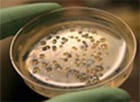

Labs, Groups & Facilities
Labs & Groups
Biological and Chemical Oceanography Data Management Office (BCO-DMO)
Principal Investigators: Peter Wiebe, Danie Kinkade, Mak Saito, and Adam Shepherd
BCO-DMO serves investigators funded by the NSF Geosciences Directorate (GEO) Division of Ocean Sciences (OCE) Biological and Chemical Oceanography Sections and Office of Polar Programs (OPP). BCO-DMO manages and provides access to oceanographic biogeochemical, ecological, and complementary physical data and information generated through scientific research funded by these NSF programs. Contact: info@bco-dmo.org
Coastal Groundwater Geochemistry
Principal Investigator: Matthew Charette
The main research goal of the Coastal Groundwater Geochemistry group is to better understand the impact of submarine groundwater discharge on chemical cycles in coastal ocean systems. Specifically, we are interested in the chemical cycles of naturally occurring radioisotopes (e.g. radium, radon), trace metals (e.g. barium, uranium), and nutrients (e.g. nitrate, phosphate).
Global Rivers Observatory
WHOI and the nearby Woods Hole Research Center, in collaboration with partners worldwide, have been operating time-series observatories on 15 large rivers since 2003 with the goal of observing the changing biogeochemical signals transmitted by river systems to the coastal ocean. We maintain a growing river sediment and water archive.
NIRVANA Lab
The Non-traditional Isotope Research on Various Advanced Novel Applications research group focuses on understanding the patterns, processes, and mechanisms of geochemical processes taking place from the core of the Earth to the edge of the Solar System.
Microbial Biogeochemistry Group
Scientists in the microbial biogeochemistry group at WHOI are studying microbes and microbial processes in environments as different as boiling hot deep sea hydrothermal vents and subzero arctic permafrost.
Molecular Environmental Science
Principal Investigator: Elizabeth Kujawinski
The lab combines research in analytical chemistry, chemical oceanography, microbiology and microbial ecology to elucidate the controls on dissolved organic matter composition in aquatic systems.
Ocean Carbon and Biogeochemistry (OCB) Program
OCB is a dynamic network of scientists working across disciplines such as ocean chemistry, biology, and physics to understand the ocean’s role in the global carbon cycle and how marine ecosystems and biogeochemical cycles are responding to environmental change.
SEA-AER Group: The Development of Aerosol & Rainwater Samplers and Sensors for Ocean Buoys
Principal Investigator: Edward Sholkovitz
Collectors and sensors on buoys are a new line of research tools for the oceanic and atmospheric community. Buoys have potential to be new platforms from which to determine the temporal and spatial variations of the aerosol composition entering and leaving oceans and of the rainwater composition entering the oceans. In tandem, aerosol and rainwater sensors are being developed to provide real-time and time-series data on atmospheric concentrations and fluxes of important biogeochemical elements, iron in particular..
U.S Joint Ocean Global Flux Study (JGOFS)
The U.S. launched the Joint Global Ocean Flux Study (JGOFS) in the late 1980s to study the ocean carbon cycle. An ambitious goal was set to understand the controls on the concentrations and fluxes of carbon and associated nutrients in the ocean.
Research Facilities
Café Thorium Radioanalytical Facility
This facility provides analytical support for the detection of natural and artificial radionuclides in environmental samples. Special emphasis is placed upon those isotopes that are used as tracers of marine process, and are commonly measured by detection of gamma, beta and alpha counting techniques.
Fourier-Transform Mass Spectrometry (FT-MS) Facility
The Fourier-Transform Mass Spectrometry facility was established in 2007 with support from the National Science Foundation and the Gordon and Betty Moore Foundation. It provides services for marine and terrestrial biogeochemists of the Woods Hole Oceanographic Institution and the greater scientific community whose sample analyses require the ultrahigh resolution and mass accuracy of FT-ICR mass spectrometry.
Isotope Geochemistry Facility
The Isotope Geochemistry Facility was created in 1998 to provide state of the art noble gas abundance and isotope ratio measurements to the research community for a variety of materials, including seawater and fresh waters, as well as rocks and minerals.
Nutrient Analytical Facility
The Woods Hole Oceanographic Institution Nutrient Analytical Facility utilizes several state of the art methods and instruments for quantifying bio-element concentrations in environmental samples.
Organic Mass Spectrometry Facility
The Organic Mass Spectrometry Facility provides specialized, state-of-the-art analytical services using instruments which would be prohibitively expensive for any single investigator to develop, operate and maintain. This facility primarily serves members of the WHOI Department of Marine Chemistry and Geochemistry, but is available to all investigators at the Institution and, as time and resources permit, to other researchers outside of the Woods Hole community.
WHOI Plasma Facility
The WHOI Plasma Facility measures an impressive variety of isotope ratios as well as major, trace, and rare earth element concentrations.